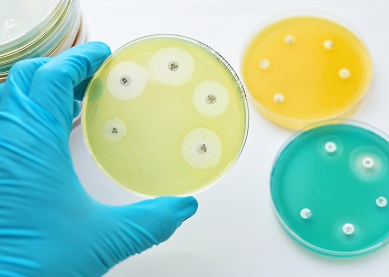

+33 (0) 3 20 16 91 40
EQA dedicated to Antimicrobial Susceptibility Testing
Body
Specific EQA to assess your Antimicrobial Susceptibility Testing:
Specific EQA to assess your Antimicrobial Susceptibility Testing:
- 118 Antimicrobial Susceptibility Testing by diffusion - disk method
- 118A Antimicrobial Susceptibility Testing by diffusion - gradient method (MIC strips)
- 118B Antimicrobial Susceptibility Testing - Broth microdilution method
- 118C Antimicrobial Susceptibility Testing - RAST method
